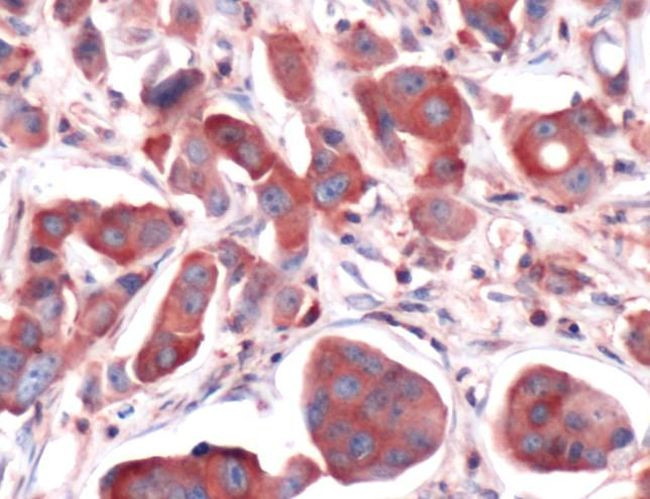
Calpain S1 Antibody in Immunohistochemistry (IHC)

Search
Invitrogen
Calpain S1 Polyclonal Antibody
{{$productOrderCtrl.translations['antibody.pdp.commerceCard.promotion.promotions']}}
{{$productOrderCtrl.translations['antibody.pdp.commerceCard.promotion.viewpromo']}}
{{$productOrderCtrl.translations['antibody.pdp.commerceCard.promotion.promocode']}}: {{promo.promoCode}} {{promo.promoTitle}} {{promo.promoDescription}}. {{$productOrderCtrl.translations['antibody.pdp.commerceCard.promotion.learnmore']}}
产品信息
PA5-32285
宿主/亚型
分类
类型
抗原
偶联物
形式
保存条件
运输条件
RRID
产品详细信息
Heat-mediated antigen retrieval is recommended prior to staining, using a 10mM citrate buffer, pH 6.0, for 10 minutes followed by cooling at room temperature for 20 min. Following antigen retrieval, incubate samples with primary antibody for 30 min at room temperature. A suggested positive control is breast ductal carcinoma.
靶标信息
Calpains are a ubiquitous, well-conserved family of calcium-dependent, cysteine proteases. Calpain families have been implicated in neurodegenerative processes, as their activation can be triggered by calcium influx and oxidative stress. Calpain I and II are heterodimeric with distinct large subunits associated with common small subunits, all of which are encoded by different genes. Calpain S1 is a small subunit common to both calpain I and II and is associated with myotonic dystrophy.
仅用于科研。不用于诊断过程。未经明确授权不得转售。